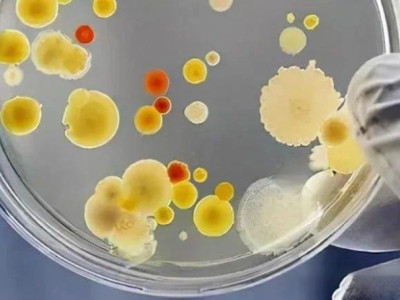
How important is high-performance bacterial strains? Whether it can make money, whether the product is stable or not, and whether it can expand its scale, mostly depends on its "ability"!

Home / All
News Group
Categories
- Lab fermenter(SS316, 5L-50L)
- Industrial Fermenter Bioreactor Antibiotic Stainless Steel Bioreactor Laboratory Fermentation Tank
- Fermentor Cell Culture Bioreator Laboratory Fermenter Bioreactor Fermentation Bioreactor
- Bioreactor Cell Microbial Culture Biofermentation Tank
- Bioreactor Bioreactor Fermenter Bioreactor Fermentor
- Small Scale Methanol Plant For Laboratory Multi Bioreactor Pressure Fermentation
- International Technology Cell Culture Bioreactor
- Benchtop Multiple Bioreactor-MINI International Technology Cell Culture Bioreactor
- Airlift Bioreactor Fermentor Cell Culture Bioreator Laboratory Fermenter Bioreactor Fermentation Bioreactor
- Stainless Steel Bioreactor Customize Fermenter bioreactor industrial Fermentor
- Industrial Fermenter Bioreactor Industrial Fermenter Laboratory Fermentation Tank
- A Small Fermentation Tank Fermentation Equipment Stirred By A Biological Fermentation Tank
- Stainless steel Cell Culture Fermenter Fermentor Bioreactor
- Cell Culture Fermentation Tank microorganism Fermentation Tank 60l Stainless Tank Fermenter
- Stainless Steel Multiple-Step Fermentor Bioreactor Bioreactor Fermenter Bioreactor Fermentor
- Stainless Steel Solid Fermentor Cell Culture Parallel Multiple Bioreactor
- Stainless Steel Parallel Bioreactor Fermentation Bioreactor
- Single-Use Bioreactor Stainless Steel Mechanical Stirring Bioreactor bioreactor Stirred Tank fermentation Process Fermenter
- Industrial Fermenter Bioreactor Antibiotic Stainless Steel Bioreactor Laboratory Fermentation Tank
- Industry fermenter(1KL-400KL)
- CIP station
- Lab glass fermenter 2L-40L
- CIP station Laboratory Bioreactor cell Culture Bioreactor Bioreactor
- Stainless Steel Fermenter Bioreactor Industrial Fermenter Bioreactor Plant Cell Cultivation Bioreactor
- 200l Industrial Batch Fermentation Bioreactor For Microbiology
- Bioreactor Batch Fermentation Bioreactor For Microbiology
- Stainless Steel For Microorganism Cultivation Bioreactor
- Steam Generator Pharma Manufacturing Bioreactor bioreactor Perfusion System 200 Liter Stainless Conical Fermenter
- Spray Dryer Fermentor Cell Culture Bioreator Laboratory Fermenter Bioreactor Fermentation Bioreactor
- Mammalian cell bioreactor(5L-10KL)
- Lab Fermenter Bioreactor Industrial Stainless Steel Fermenter
- Vaccine Fermenter(GMP) Fermentation Equipment stainless Steel Bioreactor
- Mini Lab Glass Fermenter Magnetic Mixing Cell Culture Fermenter Bioreactor
- CIP Station Automatic Bioreactor Fermenter
News
- Lianyungang Daily: This' Chinese tank 'is rapidly moving towards the world!Bailun Biology: This' Chinese jar 'is rapidly moving towards the worldOct 24,2025
- Academician Chen Jian: Synthetic biology will change the way cosmetic raw materials are produced, providing a key opportunity for domestic products to break through the bottleneck dilemma!Chen Jian, an academician of the CAE Member and a professor of Jiangnan University, made a judgment at the 2025 annual meeting of China's fragrance essence cosmetics industryOct 23,2025
- The three core cornerstones of biomanufacturingIt can be understood as a new industrial revolution, with its core features being greener, more efficient, and more sustainableOct 22,2025
- Earning 126.4 billion in just six months! Simeglutide kicks K drug and firmly sits on the throne of global medicine kingIn the first half of 2025, Novo Nordisk achieved strong performance with its Simeglutide series products.Oct 21,2025
- Academician Huang He: The breakthrough of synthetic biology lies in the core bacterial species!Huang He, academician of the CAE Member, pointed out at the 17th China Bioindustry ConferenceOct 20,2025
- 4 indicators to achieve fermentation accuracy! Testing bacterial cells, controlling dissolved oxygen, determining endpoint... all the dry goods are hereHow to evaluate the accuracy of fermentation? You can refer to the following indicators.Oct 17,2025
- AI+automation - the future path of bioreactors: from precision fermentation to smart pharmaceuticalsAfter the discovery of penicillin in 1928, it was almost useless due to difficulties in mass production. It was not until 1944 that deep tank fermentation technology realized its large-scale production - the core value of bioreactors, which has always revolved around "achieving target product scale more efficiently".Oct 16,2025
- Fermentation experiment - Effect of different stirring combinations on the production performance of L-threonineFermentation experiment of L-threonine production by Escherichia coli using different stirring combinationsOct 15,2025
- Popular understanding of the 2025 Nobel Prize in Medicine! The strength of the immune system lies not only in its ability to attack, but also in its ability to restrain itself!To understand this year's Nobel Prize, we need to first understand why the immune system "hits its own people"?Oct 14,2025
- How can the popular "bioactive supplements" in the United States deceive the intestines and simulate human metabolism?The dietary supplement market in the United States is undergoing a transformation centered around "biological activity".Oct 13,2025
- Simeglutide: From Lizard Venom to Global Medicine King, the Path to Sealing the Gods of a Generation of Divine MedicinesIn 1992, American scientists accidentally discovered a peptide called "GLP-1" in the venom of the Gila lizard, a species of venomous lizard that lives in the deserts of North America. This substance can effectively stimulate insulin secretion and lower blood sugar.Oct 10,2025
- A study of 1.71 million people shows that semaglutide reduces the risk of dementia by 46%When it comes to semaglutide, the first reaction of most people is to become a popular "weight loss miracle drug" on social media - it has become a "hot commodity" in the fitness and beauty circles due to its significant weight loss effect.Oct 9,2025
- What is the Anti Aging Artifact - Explosive NMN? What are the effects of nicotinamide mononucleotide? How to take it? Explain clearly in one articleRecently, many people have been posting NMN on their social media, claiming to be the "anti-aging tool" and "anti-aging treasure".Oct 8,2025
- How does gut microbiota affect health? Diabetes, fatty liver, colorectal cancer, inflammation may be related!The human gut is home to billions of microorganisms, which not only assist digestion but also regulate core physiological processes such as immunity and metabolism through molecular signals. Their imbalance is closely related to various diseases.Oct 7,2025
- Differences in the use of GLP-1 among different populations, how to use it in combination, and what are the dual uses? (Simeglutide, Tilpotide)GLP-1 drugs have become "star drugs" due to their dual effects of sugar control and weight lossOct 6,2025
- Why is medical beauty booming, but the fermentation process is difficult to die? Analyze the 4 core bacterial strains and 3 major bottlenecks!In the medical beauty and health industry, biological reaction strains are widely used in raw material production, skincare product research and development, and medical scenarios through technologies such as biological fermentation and metabolic regulation.Oct 3,2025
- Currently, there are 7 major challenges in precise fermentation! Amplification process, data-driven, cost efficiency, market acceptance, interdisciplinary ...Precision fermentation as an emerging biomanufacturing technologyOct 2,2025
- Introduction to the Biological Synthesis Method of "Liquid Gold" Royal JellyWhen 'liquid gold' meets synthetic biology.Oct 1,2025
- Ministry of Industry and Information Technology announces 36 bio manufacturing landmark products (see attached table)Ministry of Industry and Information Technology announced the list of iconic products in the field of biomanufacturingSep 30,2025
- Natural vs. synthetic astaxanthin: price difference of 3 times, effect difference of 10 times? Detailed explanation of the biosynthesis method of astaxanthin (red haired yeast)Astaxanthin is a high-value terpene antioxidant, with natural sources including algae, yeast, and marine organisms.Sep 29,2025
- First for the IPO of Dagang Stock: Challenging Simeglutide? How popular is the weight-loss drug track? Biopharmaceuticals are reshaping the weight loss trackHangzhou first submitted a form to the Hong Kong Stock Exchange for Dahua Biotechnology, aiming to become the first stock in weight management for the Hong Kong stock marketSep 26,2025
- Billion dollar track | Microbial fermentation method of hyaluronic acidHyaluronic acid (HA), also known as hyaluronic acidSep 25,2025
- How to produce semaglutide and how high is the cost? The core ingredients of Ozempic and Wegovy, dual effect drugs for reducing blood sugar and weightI want to know about the "dual effect hypoglycemic and weight reducing drug" semaglutide (the core ingredient of Ozempic and Wegovy)Sep 24,2025
- How important is high-performance bacterial strains? Whether it can make money, whether the product is stable or not, and whether it can expand its scale, mostly depends on its "ability"!High performance bacterial strains are the key to the industrialization of biomanufacturing.Sep 23,2025
- How to combine 9 types of fermented traditional Chinese medicine and 8 core microbial strains to achieve reduced toxicity, increased efficiency, and better absorption?The core of fermented traditional Chinese medicine is "using microorganisms as tools and traditional Chinese medicine ingredients as substrates", and the differences in ingredients of different traditional Chinese medicines determine the selection of bacterial strains.Sep 22,2025
- Production methods and huge market for biodegradable materials - polyhydroxyalkanoates (PHA)Multiple bioreactors from Bailun have appeared in the news reports!Sep 19,2025
- Five popular traditional Chinese medicines undergo liquid fermentation, including Sanghuang, Dendrobium, Poria cocos, Ginseng, and Cordyceps, transforming from "rare" to "affordable"In the big health industry, "liquid fermentation" is a key technology for revitalizing traditional Chinese medicine.Sep 18,2025
- How to choose a suitable bioreactor? A comprehensive guide from laboratory to industrialization!In the fields of biopharmaceuticals, cell therapy, enzyme catalysis, etc., bioreactors are the core equipment for achieving efficient biotransformation.Sep 17,2025
- Summarize the core of fermentation process control in one sentenceSummarize the core of biological reactions and fermentation control in one sentenceSep 16,2025
- Three key techniques for selecting drain valves and welding stressIn the operation and maintenance of industrial steam equipment, the selection of drain valves and the control of welding residual stress are two inseparable matters.Sep 15,2025
Navigation
Categories
- Lab fermenter(SS316, 5L-50L)
- Industrial Fermenter Bioreactor Antibiotic Stainless Steel Bioreactor Laboratory Fermentation Tank
- Fermentor Cell Culture Bioreator Laboratory Fermenter Bioreactor Fermentation Bioreactor
- Bioreactor Cell Microbial Culture Biofermentation Tank
- Bioreactor Bioreactor Fermenter Bioreactor Fermentor
- Small Scale Methanol Plant For Laboratory Multi Bioreactor Pressure Fermentation
- International Technology Cell Culture Bioreactor
- Benchtop Multiple Bioreactor-MINI International Technology Cell Culture Bioreactor
- Airlift Bioreactor Fermentor Cell Culture Bioreator Laboratory Fermenter Bioreactor Fermentation Bioreactor
- Stainless Steel Bioreactor Customize Fermenter bioreactor industrial Fermentor
- Industrial Fermenter Bioreactor Industrial Fermenter Laboratory Fermentation Tank
- A Small Fermentation Tank Fermentation Equipment Stirred By A Biological Fermentation Tank
- Stainless steel Cell Culture Fermenter Fermentor Bioreactor
- Cell Culture Fermentation Tank microorganism Fermentation Tank 60l Stainless Tank Fermenter
- Stainless Steel Multiple-Step Fermentor Bioreactor Bioreactor Fermenter Bioreactor Fermentor
- Stainless Steel Solid Fermentor Cell Culture Parallel Multiple Bioreactor
- Stainless Steel Parallel Bioreactor Fermentation Bioreactor
- Single-Use Bioreactor Stainless Steel Mechanical Stirring Bioreactor bioreactor Stirred Tank fermentation Process Fermenter
- Industrial Fermenter Bioreactor Antibiotic Stainless Steel Bioreactor Laboratory Fermentation Tank
- Industry fermenter(1KL-400KL)
- CIP station
- Lab glass fermenter 2L-40L
- CIP station Laboratory Bioreactor cell Culture Bioreactor Bioreactor
- Stainless Steel Fermenter Bioreactor Industrial Fermenter Bioreactor Plant Cell Cultivation Bioreactor
- 200l Industrial Batch Fermentation Bioreactor For Microbiology
- Bioreactor Batch Fermentation Bioreactor For Microbiology
- Stainless Steel For Microorganism Cultivation Bioreactor
- Steam Generator Pharma Manufacturing Bioreactor bioreactor Perfusion System 200 Liter Stainless Conical Fermenter
- Spray Dryer Fermentor Cell Culture Bioreator Laboratory Fermenter Bioreactor Fermentation Bioreactor
- Mammalian cell bioreactor(5L-10KL)
- Lab Fermenter Bioreactor Industrial Stainless Steel Fermenter
- Vaccine Fermenter(GMP) Fermentation Equipment stainless Steel Bioreactor
- Mini Lab Glass Fermenter Magnetic Mixing Cell Culture Fermenter Bioreactor
- CIP Station Automatic Bioreactor Fermenter
News
- Lianyungang Daily: This' Chinese tank 'is rapidly moving towards the world!Oct 24,2025Bailun Biology: This' Chinese jar 'is rapidly moving towards the world
- Academician Chen Jian: Synthetic biology will change the way cosmetic raw materials are produced, providing a key opportunity for domestic products to break through the bottleneck dilemma!Oct 23,2025Chen Jian, an academician of the CAE Member and a professor of Jiangnan University, made a judgment at the 2025 annual meeting of China's fragrance essence cosmetics industry